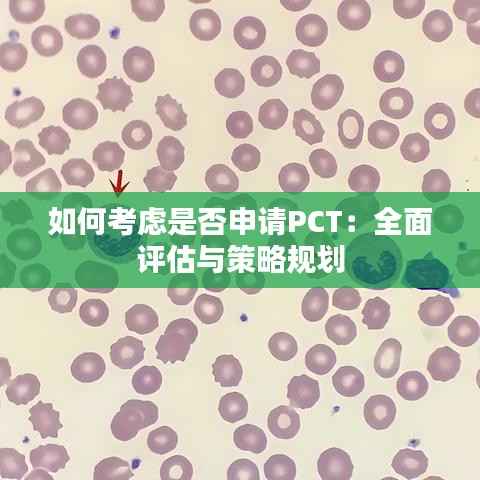

如何考虑是否申请PCT:全面评估与策略规划
什么是PCT申请?
PCT(国际专利申请)是指根据《专利合作条约》(Patent Cooperation Treaty)提出的国际专利申请。PCT申请允许申请人将一项发明在一个国家或地区提交的专利申请,转化为向多个国家或地区提出专利申请的统一过程。PCT申请的优势在于,它为发明人提供了在全球范围内寻求专利保护的机会,同时也简化了专利申请的流程。
申请PCT的考虑因素
在决定是否申请PCT之前,以下因素需要被综合考虑:
1. 发明的创新性和实用性
首先,需要评估发明的创新性和实用性。如果发明具有显著的创新性和实用性,那么在全球范围内寻求专利保护将更有价值。
2. 市场潜力
考虑发明的市场潜力。如果发明有望在全球多个市场销售,那么申请PCT可以确保在关键市场获得专利保护。
3. 竞争对手的专利布局
研究竞争对手的专利布局,了解他们在哪些国家或地区已经申请了专利。这有助于确定申请PCT的必要性和优先顺序。
4. 资金和时间成本
申请PCT需要支付一定的费用,并且需要投入时间和精力。评估自己的财务状况和时间安排,确保能够承担这些成本。
5. 国际合作与法律环境
考虑目标国家的法律环境和国际合作的可能性。不同的国家或地区可能有不同的专利法律和程序,这可能会影响PCT申请的成功率。
申请PCT的步骤
一旦决定申请PCT,以下步骤需要遵循:
1. 准备申请文件
准备完整的PCT申请文件,包括专利请求书、说明书、权利要求书、摘要等。
2. 选择国际检索单位
选择一个国际检索单位进行检索,以确保发明的新颖性和非显而易见性。
3. 提交申请
在规定的期限内向国际专利局提交PCT申请。
4. 国际检索和初步审查
国际检索单位和审查员将对申请进行检索和初步审查。
5. 国家阶段的进入
在规定的期限内,申请人需要向每个希望获得专利保护的国家或地区提交国家阶段的申请。
总结
申请PCT是一个复杂的过程,需要综合考虑多种因素。通过全面评估发明的创新性、市场潜力、竞争对手的布局以及自身的财务和时间成本,可以做出是否申请PCT的明智决策。同时,遵循正确的申请步骤,确保PCT申请的成功。在全球化竞争日益激烈的今天,申请PCT可以为发明人提供宝贵的全球专利保护,从而在市场上占据有利地位。
转载请注明来自无锡市先进制造产业知识产权运营服务平台,本文标题:《如何考虑是否申请PCT:全面评估与策略规划》

苏ICP备2021053023号-1
苏ICP备2021053023号-1